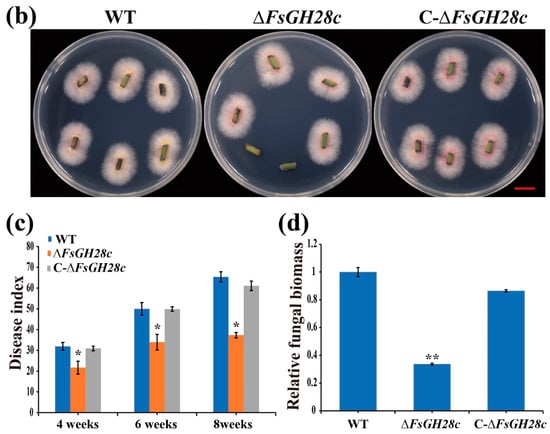

Abstract
Pathogens deploy various molecular mechanisms to overcome host defenses, among which glycoside hydrolases (GHs) play a critical role as virulence factors. Understanding the functional roles of these enzymes is essential for uncovering pathogen–host interactions and developing strategies for disease management. Fusarium wilt has occurred in the main Piper nigrum cultivation regions, which seriously affects the yield and quality of P. nigrum. Here, we identified and characterized FsGH28c, a GH28 family member in Fusarium solani. Its expression was significantly upregulated during the infection of black pepper (Piper nigrum) roots by F. solani cv. WN-1, indicating its potential role in pathogenicity. FsGH28c elicited cell death in Nicotiana benthamiana and modulated the expression of genes related to pathogenesis. FsGH28c exerts a positive influence on the pathogenicity of F. solani. The knockout of FsGH28c mutant strains markedly attenuated F. solani ’s virulence in black pepper plants. The knockout mutant strains decrease the ability of F. solani to utilize carbon sources. The FsGH28c deletion did not affect mycelial growth on PDA but did impact spore development. We identified a U-box protein, PnPUB35, interacting with FsGH28c using yeast two-hybrid and bimolecular fluorescence complementation assays. PnPUB35 conferred enhanced resistance to F. solani in black pepper through positive regulation. These findings suggest that FsGH28c may function as a virulence factor by modulating host immune responses through its interaction with PnPUB35.
1. Introduction
To breach the initial physical plant cell wall barrier, plant pathogens excrete cell wall-degrading enzymes (CWDEs), such as glycoside hydrolases [,]. While certain CWDEs augment pathogen virulence, others may trigger immune responses in plants [,]. For instance, the sucrose nonfermenting 1 gene (VdSNF1) of Verticillium dahliae [], the pectate lyase gene CcpelA of Colletotrichum coccodes [], and the pectate lyase gene VdPEL1 of V. dahliae [] were the CWDEs that play an important role in pathogen virulence. On the other hand, the secreted xyloglucanase BcXYG1 from Botrytis cinerea [] and the xyloglucan-specific endoglucanase PsXEG1 from Phytophthora sojae [] act as CWDEs to induce the immune responses of the host during pathogen infection. The symbiosis between pathogens and host plants is highly dynamic, with pathogenic pressure serving as a driving force for the evolution of plant immune mechanisms [].
Glycoside hydrolases (GHs) are ubiquitous enzymes that cleave glycosidic bonds in cellulose, hemicellulose, and pectin components of plant cell walls []. In plants, GHs are key regulators of growth and development [,]. Pathogens exploit this mechanism by secreting GHs to facilitate the penetration of plant cell walls during infection [,]. For example, the soybean GH12 enzyme PsXEG1 from P. sojae promotes virulence, while the host protein GmGIP1 inhibits PsXEG1 and increases resistance []. Other examples include GH12 proteins VdEG1/VdEG3 and GH27 protein VdGAL4 from V. dahliae, which induce cell death and immune responses in Nicotiana benthamiana [,]. Polygalacturonases (PGs) in the GH28 family degrade pectin and regulate virulence and immunity in fungi like B. cinerea, Lasiodiplodia theobromae, and V. dahliae [,,,]. In B. cinerea, BcPG1 and BcPG2 play an important role in virulence [,]. In Alternaria citri, an endoPG mutant strain decreases the pathogen on citrus []. LtEPG1 of L. theobromae plays a crucial role in pathogenesis by facilitating pectin degradation and modulating the immune response, thereby promoting successful infection in Vitis vinifera []. The VdEPG1 mutant strain significantly decreases the pathogenicity of V. dahliae in cotton []. However, the molecular function of GH28 family members in Fusarium solani is still unclear.
The ubiquitin proteasome system contains the E1 ubiquitin-activating enzyme, E2 ubiquitin-conjugating enzyme, and E3 ubiquitin ligase enzyme []. E3 ligases are identified into four types: HECT, RING, U-box, and SCF in plants []. Plant U-box E3 ubiquitin ligases (PUBs) regulate growth, development, and stress responses in plants [,,,]. PUBs contained a conserved U-box domain [], and 64 PUB members have been identified in Arabidopsis []. Some characterized PUBs act as negative regulators of immunity, like PUB22, PUB25/PUB26 in Arabidopsis and GhPUB17 in cotton, which suppress PAMP-triggered immunity or resistance to V. dahliae [,]. PUB25 and PUB26 also regulated Arabidopsis freezing tolerance and petal growth [,]. In cotton, GhPUB17 negatively regulated the cotton resistance to V. dahliae, and GhCyP3 can inhibit its E3 ligase activity []. However, other PUBs positively regulate defenses, including soybean GmSAUL1 (a bona fide U-Box E3 ligase) and apple MdPUB29, which confer resistance to pathogens by modulating cell death, immunity, and salicylic acid signaling [,]. Collectively, PUB E3 ligases serve as key regulators in the modulation of plant disease resistance.
The fungal pathogen Fusarium solani causes destructive wilt disease in the globally significant crop black pepper []. A previous study identified the F. solani strain WN-1 as the causal agent of black pepper Fusarium wilt in China []. Here, we found that the glycoside hydrolase gene FsGH28c is highly induced during WN-1 infection. Glycoside hydrolases like FsGH28c can function as virulence factors in other pathosystems. Additionally, plant U-box E3 ligases have emerged as key regulators of immunity during pathogen infection. However, the role of FsGH28c and its potential interplay with host U-box proteins in black pepper remains unknown. Investigating the function of FsGH28c and its interaction with host factors, such as U-box E3 ligases, is expected to yield critical insights into the molecular mechanisms underlying Fusarium wilt pathogenesis in black pepper. In this study, we characterize the virulence function of FsGH28c and identify a black pepper U-box protein that interacts with this pathogenicity factor. Our results shed light on how this glycoside hydrolase promotes virulence and engages host immunity regulators to facilitate Fusarium wilt disease.
2. Results
2.1. Identification and Expression Patterns of the GH28 Family Genes in F. solani
We identified nine glycoside hydrolase 28 (GH28) family members in the genome of Fusarium solani strain FSSC 5 MPI-SDFR-AT-0091 using HMMER searches with the Glyco_hydro_28 (PF00295) hidden Markov model from Pfam. The coding sequences of these GH28 genes ranged from 1083 to 1467 bp, encoding proteins of 360 to 488 amino acids with predicted isoelectric points from 5.34 to 9.03 and molecular weights from 37.163 to 54.062 kDa. All F. solani GH28 proteins contained a signal peptide (Table S3).
Phylogenetic analysis of GH28 family members from F. solani and other fungi, including Verticillium dahliae (11), Fusarium oxysporum (10), Colletotrichum gloeosporioides (19), Botrytis cinerea (20), Phytophthora infestans (25), Phytophthora capsici (17), and Magnaporthe oryzae (2), delineated three groups (Figure S1 and Table S4). Seven F. solani GH28s fell into Group A, while FsGH28c and FsGH28d were classified in Group B along with VdGH28-7/VdEPG1 from V. dahliae []. Group C contained no F. solani GH28 members. We also identified ten conserved motifs with distinct patterns among F. solani GH28 proteins (Figure S2) and variation in gene structure, specifically exon number (Figure S2). Figure S2b shows that FsGH28a, FsGH28b, FsGH28e, FsGH28f, FsGH28g, and FsGH28i contain motif 1 and are classified into the same clade. These results were consistent with those in phylogenetic analysis in Figure S1. In addition, Expression analysis by qRT-PCR revealed that FsGH28c (B0J15DRAFT_426735) was highly upregulated in both WN-1 spores and inoculated root samples compared to controls (Figure S3).
2.2. The FsGH28c Induced Cell Death in N. benthamiana
To determine if GH28 genes from F. solani can provoke an immune response in plants, a study utilizing Agrobacterium-mediated transient expression assays in N. benthamiana leaves was conducted, following the method described []. Transient expression analysis of nine GH28 genes revealed that specifically, FsGH28c could induce cell death in N. benthamiana leaves (Figure 1a). This was further corroborated by semiquantitative RT-PCR, which verified the transcription of all FsGH28 genes in the host plant (Figure 1b). Notably, FsGH28c lacking its signal peptide (FsGH28c-SP) failed to elicit cell death in the leaves (Figure 1c), and similarly, truncation mutants FsGH28c-C and FsGH28c-N were unable to trigger a hypersensitive response (HR) (Figure 1c). The signal peptide of FsGH28c, spanning amino acids 1 to 17, was listed in Table S2. A yeast signal trap system assay confirmed the functionality of the FsGH28c signal peptide (Figure 1d).

Figure 1.
Identification of the cell death induced by FsGH28c in Fusarium solani: (a) Cell death assays for 9 F. solani genes in 6-week-old N. benthamiana leaves were performed by Agrobacterium-mediated transient expression. Leaves were imaged 6 days after infiltration with Agrobacterium carrying the FsGH28 genes. BAX and GFP were used as the positive and negative controls, respectively. Scale bar = 0.5 cm. (b) Semi-quantitative reverse transcription PCR analysis of transiently expressed FsGH28 genes in N. benthamiana leaves 48 h after infiltration. NbActin was used as the control. (c) Detection of the cell death activity of FsGH28c. The FsGH28c was transiently expressed in 6-week-old N. benthamiana leaves. Sq RT-PCR analysis showed that the FsGH28c was expressed in N. benthamiana leaves. The number 1 represents the sample that was only infiltrated with BAX, number 2 represents the sample that was only infiltrated with GFP, number 3 represents the sample that was infiltrated with truncation mutation FsGH28c-C, number 4 represents the sample that was only infiltrated with truncation mutation FsGH28c-N, number 5 represents the sample that was only infiltrated with FsGH28c-SP, and number 6 represents the sample that was only infiltrated with FsGH28c. NbActin was used as the control. Scale bar = 0.5 cm. (d) Confirmation of the function of the signal peptide of FsGH28c by yeast signal trap assay. Fusion of the functionality of the signal peptide of FsGH28c can grow on YPRAA medium. The functionality of the signal peptide of Avr1b was used as the positive control. (e) The qRT-PCR analysis of the pathogenesis-related genes. The blue, yellow, and grey columns represent the samples that were infiltrated by BAX, FsGH28c, and GFP at 00 h, 06 h, 12 h, and 24 h, respectively. NbActin was used as a control. Values represent means ± standard deviation of three replicates. * p < 0.05, ** p < 0.01, *** p < 0.001.
Furthermore, N. benthamiana leaves infiltrated with constructs expressing BAX, FsGH28c, and GFP were analyzed at 0, 6, 12, and 24 h post-infiltration (hpi) using RT-qPCR. The expression of pathogenesis-related marker genes NbAcre31 [], NbCYP71D20 [], NbLOX, NbPR4 [], and NbWRKY7 [] was significantly upregulated in response to FsGH28c treatment, as evidenced in Figure 1e. The expression levels of these genes were elevated in FsGH28c-infiltrated leaves compared to those infiltrated with GFP, indicating that FsGH28c activates immune responses in plants.
2.3. FsGH28c Is Required for the Utilization of Certain Carbon Sources
To investigate the role of FsGH28c in virulence, we generated knockout mutant strains ∆FsGH28c and complemented strains C-∆FsGH28c using the homologous recombination method as previous study (Figure S4a,b) []. Compared to the wild-type WN-1 (WT), the ∆FsGH28c strains showed reduced mycelial growth and conidia counts, and C-∆FsGH28c strains showed increased ability of mycelial growth and conidia production (Figure 2).

Figure 2.
FsGH28c plays an important role in utilizing carbon source: (a) Phenotype analysis of the wild-type, ∆FsGH28c, and C-∆FsGH28c strains grown on PDA and Cazpek Dox medium with sucrose, galactose, pectin, raffinose, or cellulose as the sole carbon source for 7 days. Scale bar = 3 cm. (b) The spore concentration of the wild-type, ∆FsGH28c, and C-∆FsGH28c strains grown in liquid Czapek Dox medium for 3 days. Values represent means ± standard deviation of three replicates. The asterisks represent statistical differences performed by a t-test (* p < 0.05) in comparison with the wild-type strains. (c) The mycelial growth of the wild-type, ∆FsGH28c, and C-∆FsGH28c strains on Cazpek Dox medium at 7 days. Values represent means ± standard deviation of three replicates. The measurement unit represents centimeters. The asterisks represent statistical differences performed by a t-test (* p < 0.05, ** p < 0.01, *** p < 0.001) in comparison with the wild-type strains.
To investigate the role of FsGH28c in using different carbon sources, the mycelial radial growth of WT, ∆FsGH28c, and C-∆FsGH28c strains was assessed on Czapek Dox solid medium supplemented with various carbon sources, including sucrose, galactose, raffinose, pectin, or cellulose. The ΔFsGH28c mutants displayed significantly impaired growth in a medium containing sucrose, pectin, or cellulose compared to WT, especially in a pectin medium (W-S: without sucrose; Figure 2a,c). No difference was observed between strains in raffinose or galactose medium. These results suggest that FsGH28c plays a crucial role in the vegetative growth of F. solani and the utilization of specific carbon sources, particularly pectin.
2.4. FsGH28c Is Required for Microconidia Development
Scanning electron microscopy revealed no apparent differences in mycelial morphology between WT, ΔFsGH28c, and C-ΔFsGH28c strains grown on PDA medium (Figure 3). However, microconidia of ΔFsGH28c mutants were irregularly shaped and hollow compared to the relatively plump, smooth microconidia observed in WT and C-ΔFsGH28c strains. These results indicate that FsGH28c plays an important role in F. solani conidial development.

Figure 3.
Observation of the mycelium and conidia on a scanning electron microscope: Mycelium of the wild-type, ∆FsGH28c, and C-∆FsGH28c strains grown on PDA medium for 5 days, and microconidia of the wild-type, ∆FsGH28c, and C-∆FsGH28c strains incubated in Cazpek Dox for 3 days were observed via scanning electron microscope, respectively. The red arrows point to the mycelium and microconidia of each strain. Scale bar = 20 μm.
2.5. The FsGH28c Is Required for Full Virulence on Black Pepper
To examine ∆FsGH28c virulence, Piper nigrum cv. Reyin-1 plants were inoculated with WT, ΔFsGH28c, and C-ΔFsGH28c strains. Black pepper plants inoculated with ΔFsGH28c mutants displayed only mild wilting symptoms compared to WT and complemented strains (Figure 4a). Fungal recovery assays revealed that ΔFsGH28c mutants still colonized black pepper tissues but formed fewer colonies than WT and C-ΔFsGH28c (Figure 4b). Disease index analysis showed that pepper infected with ΔFsGH28c had significantly reduced disease compared to WT and complemented infection (Figure 4c). qPCR quantification confirmed that ΔFsGH28c mutants accumulated lower fungal biomass in inoculated pepper stems versus WT and complemented strains (Figure 4d). Together, these results demonstrate that FsGH28c is important for F. solani virulence in black pepper.

Figure 4.
FsGH28c plays a positive role in the virulence of Fusarium solani: (a) Disease symptoms of black pepper after the wild-type, ∆FsGH28c, and C-∆FsGH28c strains infection. Photographs were taken at 8 weeks after fungal inoculation. Each treatment has more than 30 black peppers. Each treatment has three replicates. Scale bar = 3 cm. (b) Re-isolation of F. solani WN-1 strains from the stem of inoculated black pepper plants at 26 °C for 3 days. Scale bar = 1.5 cm. (c) Disease index of black pepper plants at 4 weeks, 6 weeks, and 8 weeks after the wild-type, ∆FsGH28c, and C-∆FsGH28c strains infection. (d) Relative fungal biomass in stems of black pepper after the wild-type, ∆FsGH28c, and C-∆FsGH28c strains infection at 8 weeks. Values represent means ± standard deviation of three replicates. The asterisks represent statistical differences performed by a t-test (* p < 0.05, ** p < 0.01) in comparison with the wild-type strains.
2.6. FsGH28c Interacts with PnPUB35
To further study the regulatory network of FsGH28c, the pGBKT7-FsGH28cSP was constructed to be used as a bait vector via Y2H assay to screen the F. solani-inoculated black pepper root cDNA library. Fourteen blue colonies on the QDO/X/A plate were selected to perform yeast colony PCR (Figure S5a). The results showed that a positive interaction was caught (Figure S5b). Through sequencing and blasting, Pn6.961 was identified (Table S5). Pn6.961 was identified to interact with FsGH28c in the Y2HGold yeast strain (Figure 5a). Pn6.961 contained a U-box domain with 49% homology with AtPUB35 (AT4G25160) (Figure S6a,b). So, Pn6.961 was named as PnPUB35 in this study. PnPUB35 was highly expressed in the stem of black pepper (Figure S6c). The PnPUB35 expression was upregulated in the root of black pepper under the WN-1 infection (Figure S6d). Bimolecular fluorescence complementation (BiFC) assays were performed to test the interaction in vivo. The Agrobacterium of FsGH28c-SP-cYFP and PnPUB35-nYFP were co-infiltrated into N. benthamiana leaves. Under laser confocal scanning microscopy, yellow fluorescent protein (YFP) localization was observed at the plasma membrane (Figure 5b). The control treatments, co-infiltrated with FsGH28c-C-cYFP and PnPUB35-nYFP, FsGH28c-N-cYFP and PnPUB35-nYFP, cYFP with PnPUB35-nYFP, and FsGH28c-SP-cYFP with nYFP, did not show fluorescence (Figure 5b). The results showed that the interaction between FsGH28c and PnPUB35 emerged in the N. benthamiana plasma membrane. FsGH28c-YFP was located in the plasma membrane, and PnPUB35-YFP was located in the nucleus in N. benthamiana leaves (Figure S7). These results showed that FsGH28c interacts with PnPUB35 in vitro and in vivo.

Figure 5.
FsGH28c interacts with the PnPUB35: (a) The interaction between FsGH28c and PnPUB35 was confirmed by Yeast two-hybrid assays. FsGH28c-SP was an SP truncation mutation, FsGH28c-C was an N-terminal truncation mutation, and FsGH28c-N was a C-terminal truncation mutation. Scale bar = 0.3 cm. (b) BiFC assay showing that the interaction between PnPUB35-nYFP and FsGH28c-SP-cYFP formed a functional YFP in the plasma membrane. Scale bar = 100 µm.
2.7. PnPUB35 Plays a Positive Role in Resistance to F. solani
To further investigate the function of PnPUB35 in resistance to F. solani, black pepper plants were infiltrated with the VIGS constructs TRV: PnPUB35 and TRV:00. The silenced seedlings were infected with F. solani WN-1. The TRV: PnPUB35 plants showed more severe symptoms than the TRV:00 plants (Figure 6a). RT-PCR and qRT-PCR tested the gene-silencing efficiency of treatment plants. The results showed that PnPUB35 was successfully silenced (Figure 6b and Figure S8). The disease index (DI) of black pepper was investigated at 4, 6, and 8 weeks after inoculation. The results showed that the DI of PnPUB35-silenced plants infected by WN-1 strains was about 64.71. While the DI of TRV:00 plants was approximately 38.63 at eight weeks (Figure 6c). Fungal biomass assays in treatment plant roots were performed by qPCR. The results showed that the fungal biomass in PnPUB35-silenced plants was more than that in TRV:00 plants (Figure 6d). Fungal recovery and callose deposition assays showed that PnPUB35-silenced plants showed more susceptible to F. solani WN-1 than TRV:00 plants (Figure 6e,f).


Figure 6.
PnPUB35 positively regulates black pepper resistance against Fusarium solani: (a) Disease symptoms of the black pepper plants after WN-1 infection. Photographs were taken at 8 weeks after inoculation. Scale bar = 2 cm. (b) The expression level of PnPUB35 in the treatment plants. Total RNA was isolated from roots at 21 days post-agroinfiltration. PnMLF1 was used as the reference. Each experiment was performed using three independent replicates (** p < 0.01). (c) Disease index of the treatment plants at 4 weeks, 6 weeks, and 8 weeks after inoculation with WN-1. Each experiment was performed using three replicates (* p < 0.05). (d) qPCR analysis of the relative fungal biomass in stems of the treatment plants at 8 weeks after WN-1 inoculation. Each experiment was performed using three replicates. Differences between groups were compared using the t-test (** p < 0.01). (e) Re-isolation of F. solani from the stem of inoculated black pepper plants at 26 °C for 3 days. Scale bar = 1 cm. (f) Callose deposition in leaves of the treatment plants at 6 weeks after WN-1 inoculation. Leaves were imaged on fluorescence microscopy. Scale bar = 200 μm.
Then, the PnPUB35-overexpression Arabidopsis plants were inoculated with F. solani WN-1. The PnPUB35-overexpression Arabidopsis plants showed more resistance to F. solani WN-1 (Figure 7a,b). In addition, less fungal biomass was detected in overexpression plants (Figure 7c). PnPUB35 was successfully detected in overexpression plants by Western blotting (Figure 7d). These results suggested that PnPUB35 contributes positively to enhancing black pepper’s resistance to F. solani.

Figure 7.
Overexpression of PnPUB35 enhances Arabidopsis thaliana resistance to Fusarium solani: (a) Disease symptoms of the A. thaliana plants after WN-1 infection. WT represents wild-type A. thaliana plants, and OEPnPUB35 represents PnPUB35 overexpression transgenic A. thaliana line plants. Photograph was taken 14 days after inoculation with WN-1. Scale bar = 1 cm. (b) The necrotic leaves rate of A. thaliana plants at 14 days after WN-1 infection. Differences between groups were compared using the t-test (* p < 0.05). (c) qPCR analysis of the relative fungal biomass in leaves of the treatment plants at 14 days after WN-1 inoculation. Each experiment was performed using three replicates. Differences between groups were compared using the t-test (* p < 0.05). (d) Western blot analysis of PnPUB35 expression in A. thaliana plants. CBB was used as the control.
3. Materials and Methods
3.1. Fungus and Plant
The F. solani strain WN-1 was propagated following the methodology outlined by our previous study [,]. This fungal strain was incubated in solid potato dextrose agar (PDA) for seven days at 25 °C, and the microconidia were inoculated into yeast extract peptone dextrose (YPD, 2% dextrose, 2% peptone, 1% yeast extract) broth and germinated at 28 °C at 160 rpm. Cultivation of black pepper plants (Piper nigrum cv. Reyin-1) occurred in a greenhouse, maintained at 28 °C, under a controlled photoperiod of 16 h light and 8 h dark, following the protocol described by [] Liu et al. Similarly, A. thaliana seedlings were cultivated in a growth chamber maintained at 24 °C under the same photoperiod of 16 h light and 8 h dark. In contrast, tobacco plants (Nicotiana benthamiana) were cultivated for six weeks at 25 °C in a greenhouse under a 14 h light and 10 h dark photoperiod to facilitate transient expression studies.
3.2. PVX Vector Construction and Transient Expression Assay
The full-length coding sequences of the FsGH28 were obtained through amplification from F. solani cDNA by specific primers. These sequences were then cloned into the PVX vector pGR107 at the ClaI-XmaI restriction sites utilizing the Hieff Clone® Universal II One step Cloning Kit (Yeasen, Shanghai, China). Subsequently, the recombinant PVX plasmids were introduced into Agrobacterium tumefaciens strain GV3101 for transient expression studies in N. benthamiana leaves. Expression levels were assessed using BAX as a positive control and green fluorescent protein (GFP) as a negative control []. Post-Agrobacterium infiltration, leaf samples were collected at specified time points (0, 6, 12, and 24 h) for RNA extraction. Symptoms were documented at six days post-infiltration (dpi). Each experimental replicate comprised three leaves from three distinct plants, with the entire procedure repeated thrice. The primer details are listed in Table S1.
3.3. Yeast Signal Sequence Trap System
The verification of the FsGH28c signal peptide’s functionality was assessed following the previously established protocol []. The signal peptide in question, along with the Avr1b signal peptide as a positive control, was respectively cloned into the pSUC2 vector. These constructs, designated as pSUC2-FsGH28cSP and pSUC2-Avr1bSP, underwent transformation into the yeast strain YTK12 and were subsequently selected on CMD-W medium. Transformants exhibiting positive growth were cultured in YPRAA (YPR Agar Medium, 1% yeast extract, 2% peptone, 2% raffinose, 2% agar) medium containing antimycin A. For negative control comparisons, the yeast strain was transformed with the empty pSUC2 vector. The specific primers utilized in these experiments are detailed in Table S1.
3.4. The Fungal Transformation Constructs
Homologous recombination facilitated the creation of the ∆FsGH28c mutants and their respective complementary strains, following the methodology reported []. Approximately 1.1 kb of upstream and downstream flanking sequences of FsGH28c, along with the hygromycin resistance cassette (HPH), were amplified from the genomic DNA of WN-1. These amplified sequences were subsequently integrated into the knockout vector B303 using the In-Fusion HD Cloning Kit (Clontech, TaKaRa, Mountain View, CA, USA) due to their overlapping regions []. For the complementary strains, the construction of plasmids was executed as per the protocol delineated [], involving the insertion of a 1.5 kb promoter of FsGH28c and its complementary DNA into the pCAMBIA1302-Neo vector, which contains the geneticin resistance cassette. Primer details are provided in Table S1.
3.5. Fungal Transformations
The resultant constructs, B303-HPH-FsGH28c for knockout and pCAMBIA1302-Neo- FsGH28c for complementation, were employed to transform F. solani protoplasts, adhering to the procedures established [,]. Approximately 1 × 108 microconidia were inoculated into YPD broth and germinated at 28 °C at 160 rpm overnight. The germlings were mixed with the enzyme mixture of Lysing Enzymes (5 mg/mL, from Trichoderma harzianum), Driselase (5 mg/mL), and Chitinase (100 µg/mL, from Streptomyces griseus). The mixture was incubated at 28 °C for 2 h at 50 rpm. The formation of protoplasts was monitored by the microscope. Protoplasts were collected and washed twice in STC50 buffer (1.2 M Sorbitol, 10 mM CaCl2, 10 mM Tris HCl pH 7.5). Each 200 µL of 2 × 107 protoplast suspension was used for each transformation.
More than 10 µg of the construct template was combined with protoplasts. This solution was placed on ice for 20 min. Then, 1.5 mL of the 60% PEG solution (60% (w/v) PEG MW 3350, 50 mM CaCl2, 50 mM Tris HCl pH 7.5) was added and mixed by gently swirling and incubated at room temperature for 20 min; 2 mL of STC50 was added to each transformation and incubated at room temperature for 2 min; and 8 mL of STC50 was added to each transformation and incubated at 28 °C for 18 h without light. The final mixture was plated onto PDA and incubated at 28 °C. The selection of transformants relied on vector-specific antibiotic resistance and was subsequently confirmed using RT-PCR. Primer details are provided in Table S1.
3.6. Carbon Source Utilization Assays
To analyze carbon source utilization of WT, ∆FsGH28c, and C-∆FsGH28c strains, sucrose (30 g/L), pectin (10 g/L), raffinose (10 g/L), cellulose (5 g/L), or galactose (10 g/L) were mixed in Czapek Dox medium without sucrose for 7 days, as described previously. The colony growth diameter was measured by the cross method. The experiment was repeated six times.
3.7. Pathogenicity
This study utilized various strains, including deletion, complementary, and wild-type strain WN-1, cultured following the protocols we previously described []. The conidial suspensions were adjusted to a standardized concentration of 1 × 107 spores mL−1. To evaluate the virulence of these strains, Piper nigrum cv. Reyin-1 plants were employed. These plants were cultivated in Hoagland’s solution under controlled conditions, with a 16 h light/8 h dark photoperiod at 28 °C. Upon development of four true leaves, the plant seedlings underwent a 30 min immersion in the spore suspension, subsequently being replanted in sterilized soil to continue growth and facilitate observation. Root and leaf samples were collected at 0, 6, 12, and 24 h post-inoculation for analysis. The WT WN-1 spores that inoculated the black pepper after 0, 6, 12, and 24 h were collected and centrifuged for qRT-PCR analysis of FsGH28 genes. Fungal recovery from black pepper stem sections was conducted 45 days post-inoculation, adhering to the methodology of [] Liu et al. Fungal biomass quantification followed the procedure detailed []. The assessment of plant wilt was quantified using a severity scale ranging from 0 (no symptoms) to 4 (1 = ≤33%, 2 = >33% and ≤66%, 3 = > 66% and ≤99%, and 4 = 100%), with intermediate values indicating increasing severity of symptoms.
The disease index (DI) for each plot was determined using the following formula:
where n0–n4 represent the number of plants manifesting each disease rating scale, and n is the total number of plants evaluated per plot. Sixty days post-inoculation, total DNA was extracted from the seedling stems for quantitative PCR analysis, with PnMLF1 (Myeloid leukemia factor 1, Pn17.1212) serving as the reference gene for black pepper, following the methodology [].
DI = [(0 × n0 + 1 × n1 + 2 × n2 + 3 × n3 + 4 × n4)/4 × n] × 100%
3.8. Scanning Electron Microscope Assay
Scanning electron microscope (SEM) observations of morphological characteristics of the mycelia and microconidia of WT, ∆FsGH28c, and C-∆FsGH28c strains were performed by using the method as previously described []. The mycelia of WT, ∆FsGH28c, and C-∆FsGH28c strains were washed with double-distilled water from 5-day-old PDA and centrifuged at 2500× g for 10 min, respectively. And the microconidia of WT, ∆FsGH28c, and C-∆FsGH28c strains from YPD broth (germinated at 28 °C at 160 rpm for 3 days) were centrifuged at 2500× g for 10 min, respectively. The samples were treated with 0.5% DMSO. The mycelia and microconidia were first immersed in 2.5% glutaraldehyde and stored at 4 °C overnight. Subsequently, the samples were washed in 1× PBS buffer (Solarbio, pH 7.2) and dehydrated using a graded ethanol series of 30%, 50%, 75%, 95%, and 100%. Following critical point drying, the dried samples were observed using scanning electron microscopy (Hitachi SU-3000, Tokyo, Japan), respectively.
3.9. Yeast Two-Hybrid Assays
The construction of a cDNA library from black pepper roots post-inoculation with F. solani WN-1 was accomplished utilizing the Matchmaker Gold Yeast Two-Hybrid (Y2H) System (Clontech, Cat. No. 630489, TaKaRa, Mountain View, CA, USA) for the purpose of Y2H screening. Within this framework, the FsGH28c-SP gene was integrated into the pGBKT7 vector as bait to facilitate the screening of interacting proteins from the cDNA library. To substantiate the interaction between FsGH28-3 and the newly identified protein PnPUB35, the pGBKT7 plasmid harboring the FsGH28c-SP fusion was introduced into the Y2H yeast strain. Concurrently, the pGADT7 plasmid containing PnPUB35 was transformed into the Y187 yeast strain using the specified Transformation System (Clontech, Cat. No. 630489, TaKaRa, Mountain View, CA, USA). Following transformation, mating of the strains was executed, and selection was carried out on SD-Leu-Trp and SD-Leu-Trp-His-Ade media supplemented with X-α-gal, adhering to the protocols delineated in the Clontech manual (Cat. No. 630489, TaKaRa, Mountain View, CA, USA). The primers utilized are enumerated in Table S1.
3.10. BiFC Analysis and Subcellular Localization
In the study, to elucidate the in vivo interaction between FsGH28c and PnPUB35, bimolecular fluorescence complementation (BiFC) analysis was used, as previously described []. The coding sequences for FsGH28c-SP (18–1083 bp), FsGH28c-C (18–540 bp), and FsGH28c-N (541–1083 bp) were cloned into the vectors pXY104cYFP, and the coding sequences of PnPUB35 were cloned into the vectors pXY106nYFP, respectively. Subsequently, A. tumefaciens strain GV3101 harboring the recombinant constructs FsGH28c-SP-cYFP and PnPUB35-nYFP was co-infiltrated into N. benthamiana leaves to facilitate in planta expression. To ascertain the subcellular localization of the proteins, fusion constructs of FsGH28c and PnPUB35 with the reporter gene YFP were generated in the vector pCAMBIA2300-YFP. The resulting positive bacterial cultures were then infiltrated into N. benthamiana leaves. Fluorescence signals of YFP were detected at 488 nm, using a confocal microscope 48 h post-infiltration. The details of the primers utilized are delineated in Table S1.
3.11. Virus-Induced Gene Silencing (VIGS)
To further investigate the functions of PnPUB35, the VIGS method was utilized. The coding sequence (CDS) of PnPUB35, amplified from Piper nigrum cv. Reyin-1, was cloned into the tobacco rattle virus (TRV) vector pYL156, yielding the construct TRV: PnPUB35, following the methodology []. The TRV:00 construct served as the negative control. These TRV constructs were infiltrated into the leaves of black pepper seedlings, adhering to the protocol established []. To evaluate the silencing efficiency of PnPUB35, new leaves from both TRV: PnPUB35 and TRV:00 lines were examined. Plants in which PnPUB35 was successfully silenced underwent inoculation with the wild-type F. solani strain WN-1, consistent with procedures previously detailed []. Disease Index (DI), fungal recovery, and fungal biomass assays were conducted in accordance with the methods described by [] Liu et al.
3.12. Callose Deposition
Callose deposition was evaluated using aniline blue staining, following the method described []. Leaves were first destained in a 3:1 ethanol/acetic acid solution for 3 h, then sequentially treated with 70% and 50% ethanol for 2 h each. Subsequently, the leaves were rinsed in distilled water for 12 h and further destained in 10% (w/v) NaOH for 2 h. Finally, the samples were stained with 0.01% (w/v) aniline blue and visualized under fluorescence microscopy. Primer sequences are provided in Table S1.
3.13. Arabidopsis Transformation
The CDS of PnPUB35 was subcloned into the plant binary vector pCAMBIA2300, driven by the CaMV 35S promoter. This recombinant construct was then introduced into A. tumefaciens strain GV3101. Transformants exhibiting positive integration were selected for the transformation of Arabidopsis using the floral dip method []. Screening of the progeny was conducted on Murashige and Skoog (MS) medium containing 50 mg L−1 of the selective agent. The T3 transgenic Arabidopsis lines were validated through PCR analysis and subsequently utilized in pathogenicity assays. The specific primers used in these experiments are listed in Table S1.
3.14. Protein Extraction and Western Blotting
Protein extraction from N. benthamiana and A. thaliana leaves post-treatment followed the protocol outlined []. Treated leaves were pulverized in liquid nitrogen and homogenized with an equal volume of protein isolation buffer (62.5 mmol·L−1 Tris–HCl, pH 7.4, 10% glycerol, 2% SDS, 1 mmol·L−1 PMSF, 2 mmol·L−1 EDTA, 100 mmol·L−1 DTT). The homogenate was centrifuged at 13,000× g for 10 min at 4 °C, and added with one-fourth volume of loading buffer (50 mmol·L−1 Tris, pH 6.8, 200 mmol·L−1 DTT, 2% SDS, 0.1% bromophenol blue, 10% glycerol). The resulting supernatant was mixed with protein sample buffer and heated at boiling temperature for 5 min and was stored at −20 °C.
Total proteins were then separated via 10% sodium dodecyl sulfate-polyacrylamide gel electrophoresis (SDS-PAGE) (160 V, 80 min), and transferred onto polyvinylidene difluoride (PVDF) membranes (100 V, 60 min) for further analysis. After the membrane was incubated with antibodies, the intensity of signal was produced by the super-sensitivity ECL luminescent solution and detected by a chemiluminescence imager (Beijing Saizhi, MiniChemi610) []. The band detected by anti-GFP antibody was used as loading control.
3.15. Nucleic Acid Extraction and Expression Analysis
Total RNA was extracted using the RNAprep Pure Plant Plus Kit (Polysaccharides & Polyphenolics-rich) from TransGen Biotech (Beijing, China), following the manufacturer’s protocol. Similarly, total DNA was isolated with the Fungal DNA Kit from Omega Bio-tek (Norcross, GA, USA), according to the provided instructions. First-strand cDNA synthesis was performed using the All-in-One First-Strand cDNA Synthesis Super Mix for qPCR (TransGen Biotech, Beijing, China). Both RT-PCR and qPCR were carried out following the methodologies described [].
3.16. Bioinformatics Analysis
The Hidden Markov Model (HMM) for Glyco_hydro_28 (PF00295) was retrieved from the Pfam database to facilitate the identification of GH28 family members, applying an E-value threshold of less than 1, using HMMER version 3.1b2 software against fungal proteomes [,]. Subsequent to multiple sequence alignments executed with MUSCLE, as described, members of the GH28 family were used to construct a maximum likelihood (ML) phylogenetic tree employing MEGA X software (version 10.2.2) [,]. The fungal genome databases, including Fusarium solani, Verticillium dahliae, Magnaporthe oryzae, Phytophthora capsici, Phytophthora infestans, Fusarium oxysporum, Botrytis cinerea, and Colletotrichum gloeosporioides, were accessed and downloaded from the NCBI website (http://www.ncbi.nlm.nih.gov. URL (accessed on 22 April 2024)). The genome annotation information used in this study is in Table S2.
4. Discussion
The pathogen F. solani is phylogenetically classified within the F. solani species complex (FSSC) []. It is a soilborne fungal pathogen capable of colonizing both living and dead plant tissues, with the ability to persist in the soil for extended periods [,]. Previous studies showed that F. solani can infect many crops [,,,,]. Certain strains of F. solani have been reported to pose risks to human and animal health [,,]. Compared to humans and animals, plants have no specialized immune system. When phytopathogens infect the plants, plants induce sophisticated defense systems, PTI and ETI, to protect themselves from pathogens []. Nevertheless, the plant–pathogen interaction system, especially between F. solani and black pepper, has not yet been elucidated. In the present study, we detected that FsGH28c could induce cell death and activate plant immune responses, functioning as a key virulence factor that plays a pivotal role in fungal pathogenicity during infection, and interacted with PnPUB35 of the black pepper host.
Previous studies showed that GH members of phytopathogens were identified in many phytopathogens. Among oomycete plant pathogens, many GH12 proteins (6 to 12 per species) within the Phytophthora genus were identified []. In V. dahliae V991, six GH12 proteins were identified and further studied []. Four genes belonging to the GH28 family were found in Lasiodiplodia theobromae []. Bioinformatics analysis identified five proteins in V. dahliae (designated as VdGAL1 through VdGAL5) containing glycoside hydrolase family 27 (GH27) domains []. In our research, nine glycoside hydrolase-28 family members were found in the F. solani genome. Like the XEG1 [], VdEG1 and VdEG3 [], LtEPG1 [], and VdGAL4 [], the expression level of FsGH28c was significantly elevated in the spore suspension of F. solani WN-1 and in infected black pepper roots. This finding suggests that FsGH28c is a key contributor to the virulence of F. solani WN-1.
The agroinfiltration method is a widely employed technique for investigating plant resistance mechanisms, pathogen virulence, and the functional roles of effector genes in various plant species [,], especially to identify the fungal virulence factors that can induce the hypersensitive response [,,]. Many GH family members can trigger hypersensitive responses, like XEG1, VdEG1, VdEG3, LtEPG1, FoEG1 [], and VdGAL4. Previous studies showed that F. solani infects black pepper primarily through the roots and subsequently spreads systemically to the leaves []. These studies suggest that agroinfiltration of plant leaves can be used in F. solani. In our study, the Agroinfiltration assay of nine GH28 members of F. solani in N. benthamiana leaves showed that the FsGH28c can induce cell death. Furthermore, the pathogenesis-related genes NbAcre31, NbCYP71D20, NbLOX, NbPR4, and NbWRKY7 were activated by infiltration of FsGH28c in N. benthamiana leaves. Pathogens secreted virulence compounds to invade the host and cause plant disease symptoms []. However, in the yeast signal sequence trap system, several proteins secreted by pathogens have been identified, including VdCUT11 [], LtEPG1 [], FoEG1 [], VdHP1 [], and FoRnt2 []. In the current study, the signal peptide of FsGH28c was functional via the yeast signal sequence trap system assay. In addition, FsGH28c was highly expressed in infected black pepper roots. These suggested that FsGH28c was most likely secreted into the extracellular space during the infection of the host plant. Moreover, lacking the signal peptide, FsGH28c-SP did not trigger cell death in N. benthamiana leaves. These results suggest that FsGH28c may be secreted by F. solani and trigger plant defense responses during infection.
To attack the plant cell wall, pathogenic fungi can degrade the host cell walls. FoERG3 is associated with the biosynthesis of ergosterol, a crucial component of the fungal cell membrane that plays a key role in maintaining membrane structure and function. The deletion of FoERG3 disrupted ergosterol biosynthesis, inhibited mycelial growth, and markedly reduced the utilization efficiency of various carbon sources []. Rho2 plays a critical role in the development, stress response, and pathogenicity of F. oxysporum. The growth of Δrho2 was destroyed under cell wall disturbing stress and high-temperature stress []. GHs can hydrolyze cleaving glycosidic bonds in oligo- or polysaccharides, substrates that contain cellulose, hemicellulose, and pectin []. ΔVdGAL4 strains exhibited significantly reduced colony growth on media supplemented with raffinose and sucrose, alongside a marked decrease in the ability of VdGAL4 to hydrolyze α-1,6 glycosidic bonds []. VdEPG1 can hydrolyze pectin to produce galacturonic acid (Gal-A). When the VdEPG1 gene was silenced, the mutant strains demonstrated significantly reduced growth in media containing pectin []. In our research, mycelial growth of ΔFsGH28c strains was reduced considerably in a medium containing pectin, which indicates that FsGH28c participated in the utilization of pectin in the host cell wall during infection. Numerous studies have demonstrated that conidia and mycelium serve a critical role in the pathogenicity of pathogens in plants. VdNoxB, VdPls1, and VdSte11 deleted strains produce defective hyphopodia and display significantly decreased virulence [,]. The mycelium growth of VdERG2 knockout mutants was sparse and disordered, and the knockout mutant strains significantly reduced the virulence []. The number of conidia produced by the FocSge1 deletion mutant K09 decreased considerably, and no apparent symptoms were observed in bananas inoculated with K09 strains []. In the current study, the mycelia of FsGH28c deletion mutant strains were not obviously different from WT strains, but the microconidia showed irregular and hollow shapes. In addition, the FsGH28c deletion mutant strains reduced the ability to utilize different carbon sources. The ΔFsGH28c strains significantly reduced the pathogenicity of black pepper.
The yeast signal sequence trap system assay indicated that FsGH28c could be secreted in outer space by F. solani to interact with the black pepper host during infection. Furthermore, PnPUB35 was verified to interact with FsGH28c by Y2H and BiFC. Many candidate genes from host plants have been identified to regulate resistance against F. solani infection. In Panax notoginseng (Burk) F.H. Chen, overexpression of PnWRKY9 increased the tobacco resistance to F. solani, whereas the PnWRKY9-RNAi P. notoginseng plants increased the susceptibility to F. solani []. MdTyDC and MdWRKY40 overexpression enhances apple resistance to apple replant disease, which is caused by F. solani [,]. In cucumber, transgenic overexpressing CsMYB60 seedlings were more resistant to F. solani than the wild-type seedlings []. In our research, PnPUB35-silenced black pepper plants showed more severe symptoms of Fusarium wilt than WT plants, and PnPUB35 overexpression enhanced A. thaliana resistance to F. solani. These results indicated that PnPUB35 positively regulates the black pepper resistance to F. solani. In contrast, GhPUB17 is a negative regulator of cotton resistance to V. dahliae []. In a previous study, PUB17 was proven to positively regulate the resistance of plants to specific pathogens or their effectors through the HR-PCD pathway [,]. In addition, PUB17 is localized in the nucleus, but GhPUB17 interacts with GhCyP3 at the plasma membrane and in the nucleus. These indicated that PUBs induced different immune pathways in host plants under different pathogen infections, respectively. However, F. solani is a soilborne fungal pathogen and is phylogenetically categorized in the F. solani species complex (FSSC) group []. Its infection process is different from that of other pathogens, such as Pst DC3000 and P. infestans []. Moreover, PnPUB35 was localized in the nucleus and interacted with FsGH28c at the plasma membrane. Under exogenous application of stress, proteins could change localization in the cell. Like the PHORI in potatoes, its localization was altered from the cytosol to the nucleus in the presence of GA []. When F. solani WN-1 infected the plant, PnPUB35 was observed at the plasma membrane and in the nucleus (Figure S7) and interacted with FsGH28c to regulate the responses to F. solani infection. These demonstrated that plant PUBs act as a sophisticated factor in response to pathogen threats. In this study, the downstream signaling pathway of PnPUB35 in black pepper defense against F. solani remains to be explored.
5. Conclusions
In conclusion, our study demonstrates that FsGH28c, a member of the GH28 family in F. solani, functions as a virulence factor, eliciting immune responses in the host. It appears to modulate F. solani’s capacity to utilize carbon sources in the soil, and to influence spore development on the host’s root surface during infection. Furthermore, FsGH28c interacts with the U-box protein PnPUB35, which is known to enhance the resistance of black pepper against F. solani infection. Our findings suggest that FsGH28c not only triggers a hypersensitive response but also disrupts the interaction with PnPUB35, thereby modulating the host’s resistance to F. solani, as illustrated in Figure 8.

Figure 8.
Schematic model of the interaction between FsGH28c and PnPUB35. When Fusarium solani infects plants, F. solani secretes a virulence factor FsGH28c. FsGH28c can induce immune responses. It is a positive regulator of F. solani virulence. The PnPUB35 transfers localization from the nucleus to the plant cell membrane in the presence of F. solani, and interacts with FsGH28c to protect the plant against F. solani. The red X represents the F. solani strain without FsGH28c.
Supplementary Materials
The following supporting information can be downloaded at: https://www.mdpi.com/article/10.3390/ijms26094189/s1.
Author Contributions
Conceptualization, C.Z. (Chenchen Zhao) and S.S.; methodology, S.L. and T.X.; software, R.L. and S.L.; validation, S.G., J.Y. and C.Z. (Chong Zhang); formal analysis, T.T.; investigation, J.Y.; resources.; data curation, S.G.; writing—original draft preparation, S.L.; writing—review and editing, C.Z. (Chenchen Zhao); visualization, S.S.; supervision, S.G.; project administration, S.L.; funding acquisition, J.Y., S.L. and C.Z. (Chenchen Zhao). All authors have read and agreed to the published version of the manuscript.
Funding
This work was sponsored by the National Key Research and Development Program of China (No. 2023YFD1600200), the Hainan Provincial Natural Science Foundation of China (No. 322QN398), the National Natural Science Foundation of China (No. 31972329), the Hainan Black Pepper Agriculture Research System (No. HNARS-09), and the Special Fund for Young Talents in Henan Agricultural University (No. 30501338).
Institutional Review Board Statement
Not applicable.
Informed Consent Statement
Not applicable.
Data Availability Statement
The data that support the findings of this article are available from the corresponding author upon request.
Acknowledgments
We thank Jiahe Wu (Institute of Microbiology, Chinese Academy of Sciences) for kindly providing us with pXY104-cYFP and pXY106-nYFP vectors for BiFC; we thank Wenxiang Yang (College of Plant Protection, Hebei Agricultural University) for kindly providing us with pGR107-PVX vector; we also thank Lisen Liu (Institute of Cotton Research, Chinese Academy of Agricultural Sciences) for kindly providing us with pCAMBIA2300-YFP vector for subcellular localization.
Conflicts of Interest
The authors declare no conflicts of interest.
References
- Kikot, G.E.; Hours, R.A.; Alconada, T.M. Contribution of cell wall degrading enzymes to pathogenesis of Fusarium graminearum: A review. J. Basic Microbiol. 2009, 49, 231–241. [Google Scholar] [CrossRef] [PubMed]
- Klöckner, A.; Bühl, H.; Viollier, P.; Henrichfreise, B. Deconstructing the Chlamydial Cell Wall. Biol. Chlamydia 2018, 412, 1–33. [Google Scholar]
- Brito, N.; Espino, J.J.; González, C. The endo-beta-1,4-xylanase xyn11A is required for virulence in Botrytis cinerea. Mol. Plant-Microbe Interact. 2006, 19, 25–32. [Google Scholar] [CrossRef] [PubMed]
- Hématy, K.; Cherk, C.; Somerville, S. Host–pathogen warfare at the plant cell wall. Curr. Opin. Plant Biol. 2009, 12, 406–413. [Google Scholar] [CrossRef] [PubMed]
- Tzima, A.K.; Paplomatas, E.J.; Rauyaree, P.; Ospina-Giraldo, M.D.; Kang, S. VdSNF1, the Sucrose Nonfermenting Protein Kinase Gene of Verticillium dahliae, Is Required for Virulence and Expression of Genes Involved in Cell-Wall Degradation. Mol. Plant-Microbe Interact. 2011, 24, 129–142. [Google Scholar] [CrossRef]
- Ben-Daniel, B.; Bar-Zvi, D.; Tsror, L. Pectate lyase affects pathogenicity in natural isolates of Colletotrichum coccodes and in pelA gene-disrupted and gene-overexpressing mutant lines. Mol. Plant Pathol. 2012, 13, 187–197. [Google Scholar] [CrossRef]
- Yang, Y.; Zhang, Y.; Li, B.; Yang, X.; Dong, Y.; Qiu, D. A Verticillium dahliae Pectate Lyase Induces Plant Immune Responses and Contributes to Virulence. Front. Plant Sci. 2018, 9, 1271. [Google Scholar] [CrossRef]
- Zhu, W.; Ronen, M.; Gur, Y.; Minz-Dub, A.; Masrati, G.; Ben-Tal, N.; Savidor, A.; Sharon, I.; Eizner, E.; Valerius, O.; et al. BcXYG1, a Secreted Xyloglucanase from Botrytis cinerea, Triggers Both Cell Death and Plant Immune Responses. Plant Physiol. 2017, 175, 438–456. [Google Scholar] [CrossRef]
- Ma, Z.; Song, T.; Zhu, L.; Ye, W.; Wang, Y.; Shao, Y.; Dong, S.; Zhang, Z.; Dou, D.; Zheng, X.; et al. A Phytophthora sojae Glycoside Hydrolase 12 Protein Is a Major Virulence Factor during Soybean Infection and Is Recognized as a PAMP. Plant Cell 2015, 27, 2057–2072. [Google Scholar] [CrossRef]
- Ascurra, Y.C.T.; Zhang, L.; Toghani, A.; Hua, C.; Rangegowda, N.J.; Posbeyikian, A.; Pai, H.; Lin, X.; Wolters, P.J.; Wouters, D.; et al. Functional diversification of a wild potato immune receptor at its center of origin. Science 2023, 381, 891–897. [Google Scholar] [CrossRef]
- Kubicek, C.P.; Starr, T.L.; Glass, N.L. Plant Cell Wall–Degrading Enzymes and Their Secretion in Plant-Pathogenic Fungi. Annu. Rev. Phytopathol. 2014, 52, 427–451. [Google Scholar] [CrossRef] [PubMed]
- Lewis, M.W.; E Leslie, M.; Liljegren, S.J. Plant separation: 50 ways to leave your mother. Curr. Opin. Plant Biol. 2006, 9, 59–65. [Google Scholar] [CrossRef] [PubMed]
- Rui, Y.; Xiao, C.; Yi, H.; Kandemir, B.; Wang, J.Z.; Puri, V.M.; Anderson, C.T. POLYGALACTURONASE INVOLVED IN EXPANSION3 Functions in Seedling Development, Rosette Growth, and Stomatal Dynamics in Arabidopsis thaliana. Plant Cell 2017, 29, 2413–2432. [Google Scholar] [CrossRef] [PubMed]
- Wen, Y.; Zhou, J.; Feng, H.; Sun, W.; Zhang, Y.; Zhao, L.; Cheng, Y.; Feng, Z.; Zhu, H.; Wei, F. VdGAL4 Modulates Microsclerotium Formation, Conidial Morphology, and Germination to Promote Virulence in Verticillium dahliae. Microbiol. Spectr. 2023, 11, e0351522. [Google Scholar] [CrossRef]
- Liu, S.; Liu, R.; Lv, J.; Feng, Z.; Wei, F.; Zhao, L.; Zhang, Y.; Zhu, H.; Feng, H. The glycoside hydrolase 28 member VdEPG1 is a virulence factor of Verticillium dahliae and interacts with the jasmonic acid pathway-related gene GhOPR9. Mol. Plant Pathol. 2023, 24, 1238–1255. [Google Scholar] [CrossRef]
- Ma, Z.; Zhu, L.; Song, T.; Wang, Y.; Zhang, Q.; Xia, Y.; Qiu, M.; Lin, Y.; Li, H.; Kong, L.; et al. A paralogous decoy protects Phytophthora sojae apoplastic effector PsXEG1 from a host inhibitor. Science 2017, 355, 710–714. [Google Scholar] [CrossRef]
- Gui, Y.-J.; Zhang, W.-Q.; Zhang, D.-D.; Zhou, L.; Short, D.P.G.; Wang, J.; Ma, X.-F.; Li, T.-G.; Kong, Z.-Q.; Wang, B.-L.; et al. A Verticillium dahliae Extracellular Cutinase Modulates Plant Immune Responses. Mol. Plant-Microbe Interact. 2018, 31, 260–273. [Google Scholar] [CrossRef]
- Reignault, P.; Valette-Collet, O.; Boccara, M. The importance of fungal pectinolytic enzymes in plant invasion, host adaptability and symptom type. Eur. J. Plant Pathol. 2008, 120, 1–11. [Google Scholar] [CrossRef]
- Poinssot, B.; Vandelle, E.; Bentéjac, M.; Adrian, M.; Levis, C.; Brygoo, Y.; Garin, J.; Sicilia, F.; Coutos-Thévenot, P.; Pugin, A. The Endopolygalacturonase 1 from Botrytis cinerea Activates Grapevine Defense Reactions Unrelated to Its Enzymatic Activity. Mol. Plant-Microbe Interact. 2003, 16, 553–564. [Google Scholar] [CrossRef]
- Kars, I.; Krooshof, G.H.; Wagemakers, L.; Joosten, R.; Benen, J.A.E.; Van Kan, J.A.L. Necrotizing activity of five Botrytis cinerea endopolygalacturonases produced in Pichia pastoris. Plant J. 2005, 43, 213–225. [Google Scholar] [CrossRef]
- Isshiki, A.; Akimitsu, K.; Yamamoto, M.; Yamamoto, H. Endopolygalacturonase Is Essential for Citrus Black Rot Caused by Alternaria citribut Not Brown Spot Caused by Alternaria alternata. Mol. Plant-Microbe Interact. 2001, 14, 749–757. [Google Scholar] [CrossRef] [PubMed]
- Thilini Chethana, K.W.; Peng, J.; Li, X.; Xing, Q.; Liu, M.; Zhang, W.; Hyde, K.D.; Zhao, W.; Yan, J. LtEPG1, a Secretory Endopolygalacturonase Protein, Regulates the Virulence of Lasiodiplodia theobromae in Vitis vinifera and Is Recognized as a Microbe-Associated Molecular Patterns. Phytopathology 2020, 110, 1727–1736. [Google Scholar] [CrossRef] [PubMed]
- Vierstra, R.D. The ubiquitin–26S proteasome system at the nexus of plant biology. Nat. Rev. Mol. Cell Biol. 2009, 10, 385–397. [Google Scholar] [CrossRef] [PubMed]
- Buetow, L.; Huang, D.T. Structural insights into the catalysis and regulation of E3 ubiquitin ligases. Nat. Rev. Mol. Cell Biol. 2016, 17, 626–642. [Google Scholar] [CrossRef]
- Ye, Q.; Wang, H.; Su, T.; Wu, W.-H.; Chen, Y.-F. The Ubiquitin E3 Ligase PRU1 Regulates WRKY6 Degradation to Modulate Phosphate Homeostasis in Response to Low-Pi Stress in Arabidopsis. Plant Cell 2018, 30, 1062–1076. [Google Scholar] [CrossRef]
- Zhou, J.; Liu, D.; Wang, P.; Ma, X.; Lin, W.; Chen, S.; Mishev, K.; Lu, D.; Kumar, R.; Vanhoutte, I. Regulation of Arabidopsis brassinosteroid receptor BRI1 endocytosis and degradation by plant U-box PUB12/PUB13-mediated ubiquitination. Proc. Natl. Acad. Sci. USA 2018, 115, E1906–E1915. [Google Scholar] [CrossRef]
- Xiao, Z.; Yang, C.; Liu, C.; Yang, L.; Yang, S.; Zhou, J.; Li, F.; Jiang, L.; Xiao, S.; Gao, C.; et al. SINAT E3 ligases regulate the stability of the ESCRT component FREE1 in response to iron deficiency in plants. J. Integr. Plant Biol. 2020, 62, 1399–1417. [Google Scholar] [CrossRef]
- Ma, A.; Zhang, D.; Wang, G.; Wang, K.; Li, Z.; Gao, Y.; Li, H.; Bian, C.; Cheng, J.; Han, Y.; et al. Verticillium dahlia effector VDAL protects MYB6 from degradation by interacting with PUB25 and PUB26 E3 ligases to enhance Verticillium wilt resistance. Plant Cell 2021, 33, 3675–3699. [Google Scholar] [CrossRef]
- Pringa, E.; Martinez-Noel, G.; Müller, U.; Harbers, K. Interaction of the RING Finger-related U-box Motif of a Nuclear Dot Protein with Ubiquitin-conjugating Enzymes. J. Biol. Chem. 2001, 276, 19617–19623. [Google Scholar] [CrossRef]
- Mudgil, Y.; Shiu, S.-H.; Stone, S.L.; Salt, J.N.; Goring, D.R. A Large Complement of the Predicted Arabidopsis ARM Repeat Proteins Are Members of the U-Box E3 Ubiquitin Ligase Family. Plant Physiol. 2004, 134, 59–66. [Google Scholar] [CrossRef]
- Stegmann, M.; Anderson, R.G.; Ichimura, K.; Pecenkova, T.; Reuter, P.; Žárský, V.; McDowell, J.M.; Shirasu, K.; Trujillo, M. The Ubiquitin Ligase PUB22 Targets a Subunit of the Exocyst Complex Required for PAMP-Triggered Responses in Arabidopsis. Plant Cell 2012, 24, 4703–4716. [Google Scholar] [CrossRef] [PubMed]
- Wang, J.; Grubb, L.E.; Wang, J.; Liang, X.; Li, L.; Gao, C.; Ma, M.; Feng, F.; Li, M.; Li, L.; et al. A Regulatory Module Controlling Homeostasis of a Plant Immune Kinase. Mol. Cell 2018, 69, 493–504.e6. [Google Scholar] [CrossRef] [PubMed]
- Wang, X.; Ding, Y.; Li, Z.; Shi, Y.; Wang, J.; Hua, J.; Gong, Z.; Zhou, J.-M.; Yang, S. PUB25 and PUB26 Promote Plant Freezing Tolerance by Degrading the Cold Signaling Negative Regulator MYB15. Dev. Cell 2019, 51, 222–235.e5. [Google Scholar] [CrossRef]
- Li, J.; Zhang, Y.; Gao, Z.; Xu, X.; Wang, Y.; Lin, Y.; Ye, P.; Huang, T. Plant U-box E3 ligases PUB25 and PUB26 control organ growth in Arabidopsis. New Phytol. 2021, 229, 403–413. [Google Scholar] [CrossRef]
- Qin, T.; Liu, S.; Zhang, Z.; Sun, L.; He, X.; Lindsey, K.; Zhu, L.; Zhang, X. GhCyP3 improves the resistance of cotton to Verticillium dahliae by inhibiting the E3 ubiquitin ligase activity of GhPUB17. Plant Mol. Biol. 2019, 99, 379–393. [Google Scholar] [CrossRef]
- Li, J.M.; Ye, M.Y.; Wang, C.; Ma, X.H.; Wu, N.N.; Zhong, C.L.; Zhang, Y.; Cheng, N.; Nakata, P.A.; Zeng, L.; et al. Soybean GmSAUL1, a Bona Fide U-Box E3 Ligase, Negatively Regulates Immunity Likely through Repressing the Activation of GmMPK3. Int. J. Mol. Sci. 2023, 24, 6240. [Google Scholar] [CrossRef]
- Han, P.-L.; Dong, Y.-H.; Gu, K.-D.; Yu, J.-Q.; Hu, D.-G.; Hao, Y.-J. The apple U-box E3 ubiquitin ligase MdPUB29 contributes to activate plant immune response to the fungal pathogen Botryosphaeria dothidea. Planta 2019, 249, 1177–1188. [Google Scholar] [CrossRef]
- Hu, L.; Xu, Z.; Wang, M.; Fan, R.; Yuan, D.; Wu, B.; Wu, H.; Qin, X.; Yan, L.; Tan, L.; et al. The chromosome-scale reference genome of black pepper provides insight into piperine biosynthesis. Nat. Commun. 2019, 10, 4702. [Google Scholar] [CrossRef]
- Liu, S.; Liu, R.; Chu, B.; Li, Z.; Meng, Q.; Gou, Y.; Xue, C.; Tian, T.; Chen, P.; Wei, F.; et al. Identification and screening of fungicides against Piper nigrum basal Fusarium wilt disease in Hainan, China. J. Basic Microbiol. 2023, 63, 1254–1264. [Google Scholar] [CrossRef]
- Kiba, A.; Nakano, M.; Ohnishi, K.; Hikichi, Y. The SEC14 phospholipid transfer protein regulates pathogen-associated molecular pattern-triggered immunity in Nicotiana benthamiana. Plant Physiol. Biochem. 2018, 125, 212–218. [Google Scholar] [CrossRef]
- Heese, A.; Hann, D.R.; Gimenez-Ibanez, S.; Jones, A.M.; He, K.; Li, J.; Schroeder, J.I.; Peck, S.C.; Rathjen, J.P. The receptor-like kinase SERK3/BAK1 is a central regulator of innate immunity in plants. Proc. Natl. Acad. Sci. USA 2007, 104, 12217–12222. [Google Scholar] [CrossRef] [PubMed]
- Asai, S.; Yoshioka, H. Nitric Oxide as a Partner of Reactive Oxygen Species Participates in Disease Resistance to Necrotrophic Pathogen Botrytis cinerea in Nicotiana benthamiana. Mol. Plant-Microbe Interact. 2009, 22, 619–629. [Google Scholar] [CrossRef] [PubMed]
- Ishihama, N.; Yamada, R.; Yoshioka, M.; Katou, S.; Yoshioka, H. Phosphorylation of the Nicotiana benthamiana WRKY8 Transcription Factor by MAPK Functions in the Defense Response. Plant Cell 2011, 23, 1153–1170. [Google Scholar] [CrossRef]
- Liu, J.; Wang, C.; Kong, L.; Yang, Y.; Cui, X.; Li, K.; Nian, H. Rho2 involved in development, stress response and pathogenicity of Fusarium oxysporum. World J. Microbiol. Biotechnol. 2023, 39, 272. [Google Scholar] [CrossRef]
- Lightfoot, J.D.; Fuller, K.K. CRISPR/Cas9-Mediated Gene Replacement in the Fungal Keratitis Pathogen Fusarium solani var. petroliphilum. Microorganisms 2019, 7, 457. [Google Scholar] [CrossRef]
- Liu, L.; Wang, Z.; Li, J.; Wang, Y.; Yuan, J.; Zhan, J.; Wang, P.; Lin, Y.; Li, F.; Ge, X. Verticillium dahliae secreted protein Vd424Y is required for full virulence, targets the nucleus of plant cells, and induces cell death. Mol. Plant Pathol. 2021, 22, 1109–1120. [Google Scholar] [CrossRef]
- Jacobs, K.A.; Collins-Racie, L.A.; Colbert, M.; Duckett, M.; Golden-Fleet, M.; Kelleher, K.; Kriz, R.; LaVallie, E.R.; Merberg, D.; Spaulding, V.; et al. A genetic selection for isolating cDNAs encoding secreted proteins. Gene 1997, 198, 289–296. [Google Scholar] [CrossRef]
- Su, X.; Rehman, L.; Guo, H.; Li, X.; Zhang, R.; Cheng, H. AAC as a Potential Target Gene to Control Verticillium dahliae. Genes 2017, 8, 25. [Google Scholar] [CrossRef]
- Rehman, L.; Su, X.; Guo, H.; Qi, X.; Cheng, H. Protoplast transformation as a potential platform for exploring gene function in Verticillium dahliae. BMC Biotechnol. 2016, 16, 57. [Google Scholar] [CrossRef]
- Yu, X.; Li, L.; Guo, M.; Chory, J.; Yin, Y. Modulation of brassinosteroid-regulated gene expression by jumonji domain-containing proteins ELF6 and REF6 in Arabidopsis. Proc. Natl. Acad. Sci. USA 2008, 105, 7618–7623. [Google Scholar] [CrossRef]
- Tang, Y.; Zhang, Z.; Lei, Y.; Hu, G.; Liu, J.; Hao, M.; Chen, A.; Peng, Q.; Wu, J. Cotton WATs Modulate SA Biosynthesis and Local Lignin Deposition Participating in Plant Resistance Against Verticillium dahliae. Front. Plant Sci. 2019, 10, 526. [Google Scholar] [CrossRef] [PubMed]
- Liu, S.; Sun, R.; Zhang, X.; Feng, Z.; Wei, F.; Zhao, L.; Zhang, Y.; Zhu, L.; Feng, H.; Zhu, H. Genome-Wide Analysis of OPR Family Genes in Cotton Identified a Role for GhOPR9 in Verticillium dahliae Resistance. Genes 2020, 11, 1134. [Google Scholar] [CrossRef] [PubMed]
- Clough, S.J.; Bent, A.F. Floral dip: A simplified method for Agrobacterium-mediated transformation of Arabidopsis thaliana. Plant J. 1998, 16, 735–743. [Google Scholar] [CrossRef] [PubMed]
- Bai, H.; Lan, J.P.; Gan, Q.; Wang, X.Y.; Hou, M.M.; Cao, Y.H.; Li, L.Y.; Liu, L.J.; Hao, Y.J.; Yin, C.C.; et al. Identification and expression analysis of components involved in rice Xa21-mediated disease resistance signalling. Plant Biol. 2012, 14, 914–922. [Google Scholar] [CrossRef]
- El-Gebali, S.; Mistry, J.; Bateman, A.; Eddy, S.R.; Luciani, A.; Potter, S.C.; Qureshi, M.; Richardson, L.J.; Salazar, G.A.; Smart, A.; et al. The Pfam protein families database in 2019. Nucleic Acids Res. 2019, 47, D427–D432. [Google Scholar] [CrossRef]
- Finn, R.D.; Clements, J.; Eddy, S.R. HMMER web server: Interactive sequence similarity searching. Nucleic Acids Res. 2011, 39, W29–W37. [Google Scholar] [CrossRef]
- Edgar, R.C. MUSCLE: Multiple sequence alignment with high accuracy and high throughput. Nucleic Acids Res. 2004, 32, 1792–1797. [Google Scholar] [CrossRef]
- Kumar, S.; Stecher, G.; Li, M.; Knyaz, C.; Tamura, K. MEGA X: Molecular Evolutionary Genetics Analysis across Computing Platforms. Mol. Biol. Evol. 2018, 35, 1547–1549. [Google Scholar] [CrossRef]
- Nalim, F.A.; Samuels, G.J.; Wijesundera, R.L.; Geiser, D.M. New species from the Fusarium solani species complex derived from perithecia and soil in the Old World tropics. Mycologia 2011, 103, 1302–1330. [Google Scholar] [CrossRef]
- Da Luz, S.F.; Yamaguchi, L.F.; Kato, M.J.; De Lemos, O.F.; Xavier, L.P.; Maia, J.G.S.; Ramos, A.D.R.; Setzer, W.N.; Da Silva, J.K.D.R. Secondary Metabolic Profiles of Two Cultivars of Piper nigrum (Black Pepper) Resulting from Infection by Fusarium solani f. sp. piperis. Int. J. Mol. Sci. 2017, 18, 2434. [Google Scholar] [CrossRef]
- Kamali-Sarvestani, S.; Mostowfizadeh-Ghalamfarsa, R.; Salmaninezhad, F.; Cacciola, S.O. Fusarium and Neocosmospora Species Associated with Rot of Cactaceae and Other Succulent Plants. J. Fungi 2022, 8, 364. [Google Scholar] [CrossRef] [PubMed]
- Romberg, M.K.; Davis, R.M. Host Range and Phylogeny of Fusarium solani f. sp. eumartii from Potato and Tomato in California. Plant Dis. 2007, 91, 585–592. [Google Scholar]
- Villarino, M.; De la Lastra, E.; Basallote-Ureba, M.J.; Capote, N.; Larena, I.; Melgarejo, P.; De Cal, A. Characterization of Fusarium solani Populations Associated with Spanish Strawberry Crops. Plant Dis. 2019, 103, 1974–1982. [Google Scholar] [CrossRef]
- Gherbawy, Y.A.; Hussein, M.A.; Hassany, N.A.; Shebany, Y.M.; Hassan, S.; El-Dawy, E.G.A.E. Phylogeny and pathogenicity of Fusarium solani species complex (FSSC) associated with potato tubers. J. Basic Microbiol. 2021, 61, 1133–1144. [Google Scholar] [CrossRef]
- Li, J.; Li, C. Fusarium solani Causing Root Rot Disease on Gastrodia elata in Shaxi, China. Plant Dis. 2022, 106, 320. [Google Scholar] [CrossRef]
- O’Donnell, K.; Sutton, D.A.; Fothergill, A.; McCarthy, D.; Rinaldi, M.G.; Brandt, M.E.; Zhang, N.; Geiser, D.M. Molecular phylogenetic diversity, multilocus haplotype nomenclature, and in vitro antifungal resistance within the Fusarium solani species complex. J. Clin. Microbiol. 2008, 46, 2477–2490. [Google Scholar] [CrossRef]
- Muhammed, M.; Anagnostou, T.; Desalermos, A.; Kourkoumpetis, T.K.; Carneiro, H.A.; Glavis-Bloom, J.; Coleman, J.J.; Mylonakis, E. Fusarium infection: Report of 26 cases and review of 97 cases from the literature. Medicine 2013, 92, 305–316. [Google Scholar] [CrossRef]
- Xu, L.-J.; Xie, L.-X. Fusarium solani Activates Dectin-1 in Experimentally Induced Keratomycosis. Curr. Med. Sci. 2018, 38, 153–159. [Google Scholar] [CrossRef]
- Zipfel, C. Plant pattern-recognition receptors. Trends Immunol. 2014, 35, 345–351. [Google Scholar] [CrossRef]
- Gui, Y.; Chen, J.; Zhang, D.; Li, N.; Li, T.; Zhang, W.; Wang, X.; Short, D.P.G.; Li, L.; Guo, W.; et al. Verticillium dahliae manipulates plant immunity by glycoside hydrolase 12 proteins in conjunction with carbohydrate-binding module 1. Environ. Microbiol. 2017, 19, 1914–1932. [Google Scholar] [CrossRef]
- Kanneganti, T.-D.; Huitema, E.; Kamoun, S. In planta expression of oomycete and fungal genes. Methods Mol. Biol. 2007, 354, 35–43. [Google Scholar] [PubMed]
- Ma, L.; Lukasik, E.; Gawehns, F.; Takken, F.L.W. The use of agroinfiltration for transient expression of plant resistance and fungal effector proteins in Nicotiana benthamiana leaves. Methods Mol. Biol. 2012, 835, 61–74. [Google Scholar] [PubMed]
- Zhou, B.-J.; Jia, P.-S.; Gao, F.; Guo, H.-S. Molecular Characterization and Functional Analysis of a Necrosis- and Ethylene-Inducing, Protein-Encoding Gene Family from Verticillium dahliae. Mol. Plant-Microbe Interact. 2012, 25, 964–975. [Google Scholar] [CrossRef] [PubMed]
- Santhanam, P.; van Esse, H.P.; Albert, I.; Faino, L.; Nürnberger, T.; Thomma, B.P.H.J. Evidence for Functional Diversification Within a Fungal NEP1-Like Protein Family. Mol. Plant-Microbe Interact. 2013, 26, 278–286. [Google Scholar] [CrossRef] [PubMed]
- Zhang, L.; Yan, J.; Fu, Z.; Shi, W.; Ninkuu, V.; Li, G.; Yang, X.; Zeng, H. FoEG1, a secreted glycoside hydrolase family 12 protein from Fusarium oxysporum, triggers cell death and modulates plant immunity. Mol. Plant Pathol. 2021, 22, 522–538. [Google Scholar] [CrossRef]
- Fradin, E.F.; Thomma, B.P. Physiology and molecular aspects of Verticillium wilt diseases caused by V. dahliae and V. albo-atrum. Mol. Plant Pathol. 2006, 7, 71–86. [Google Scholar] [CrossRef]
- Zhang, X.; Zhao, L.; Liu, S.; Zhou, J.; Wu, Y.; Feng, Z.; Zhang, Y.; Zhu, H.; Wei, F.; Feng, H. Identification and Functional Analysis of a Novel Hydrophobic Protein VdHP1 from Verticillium dahliae. Microbiol. Spectr. 2022, 10, e0247821. [Google Scholar] [CrossRef]
- Qian, H.; Wang, L.; Wang, B.; Liang, W. The secreted ribonuclease T2 protein FoRnt2 contributes to Fusarium oxysporum virulence. Mol. Plant Pathol. 2022, 23, 1346–1360. [Google Scholar] [CrossRef]
- Han, S.; Sheng, B.; Zhu, D.; Chen, J.; Cai, H.; Zhang, S.; Guo, C. Role of FoERG3 in Ergosterol Biosynthesis by Fusarium oxysporum and the Associated Regulation by Bacillus subtilis HSY21. Plant Dis. 2023, 107, 1565–1575. [Google Scholar] [CrossRef]
- Zhao, Y.-L.; Zhou, T.-T.; Guo, H.-S. Hyphopodium-Specific VdNoxB/VdPls1-Dependent ROS-Ca2+ Signaling Is Required for Plant Infection by Verticillium dahliae. PLoS Pathog. 2016, 12, e1005793. [Google Scholar] [CrossRef]
- Yu, J.; Li, T.; Tian, L.; Tang, C.; Klosterman, S.J.; Tian, C.; Wang, Y. Two Verticillium dahliae MAPKKKs, VdSsk2 and VdSte11, Have Distinct Roles in Pathogenicity, Microsclerotial Formation, and Stress Adaptation. Msphere 2019, 4, 10–1128. [Google Scholar] [CrossRef] [PubMed]
- Lv, J.; Liu, S.; Zhang, X.; Zhao, L.; Zhang, T.; Zhang, Z.; Feng, Z.; Wei, F.; Zhou, J.; Zhao, R.; et al. VdERG2 was involved in ergosterol biosynthesis, nutritional differentiation and virulence of Verticillium dahliae. Curr. Genet. 2023, 69, 25–40. [Google Scholar] [CrossRef] [PubMed]
- Gurdaswani, V.; Ghag, S.B.; Ganapathi, T.R. FocSge1 in Fusarium oxysporum f. sp. cubense race 1 is essential for full virulence. BMC Microbiol. 2020, 20, 255. [Google Scholar] [CrossRef] [PubMed]
- Zheng, L.; Qiu, B.; Su, L.; Wang, H.; Cui, X.; Ge, F.; Liu, D. Panax notoginseng WRKY Transcription Factor 9 Is a Positive Regulator in Responding to Root Rot Pathogen Fusarium solani. Front. Plant Sci. 2022, 13, 930644. [Google Scholar] [CrossRef]
- Liu, Y.; Liu, Q.; Li, X.; Tang, Z.; Zhang, Z.; Gao, H.; Ma, F.; Li, C. Exogenous Dopamine and MdTyDC Overexpression Enhance Apple Resistance to Fusarium solani. Phytopathology 2022, 112, 2503–2513. [Google Scholar] [CrossRef]
- Wang, M.; Tang, W.; Xiang, L.; Chen, X.; Shen, X.; Yin, C.; Mao, Z. Involvement of MdWRKY40 in the defense of mycorrhizal apple against Fusarium solani. BMC Plant Biol. 2022, 22, 385. [Google Scholar] [CrossRef]
- Li, J.; Luan, Q.; Han, J.; Chen, C.; Ren, Z. CsMYB60 Confers Enhanced Resistance to Fusarium solani by Increasing Proanthocyanidin Biosynthesis in Cucumber. Phytopathology 2022, 112, 588–594. [Google Scholar] [CrossRef]
- He, Q.; McLellan, H.; Boevink, P.C.; Sadanandom, A.; Xie, C.; Birch, P.R.J.; Tian, Z. U-box E3 ubiquitin ligase PUB17 acts in the nucleus to promote specific immune pathways triggered by Phytophthora infestans. J. Exp. Bot. 2015, 66, 3189–3199. [Google Scholar] [CrossRef]
- Orosa, B.; He, Q.; Mesmar, J.; Gilroy, E.M.; McLellan, H.; Yang, C.; Craig, A.; Bailey, M.; Zhang, C.; Moore, J.D.; et al. BTB-BACK Domain Protein POB1 Suppresses Immune Cell Death by Targeting Ubiquitin E3 ligase PUB17 for Degradation. PLoS Genet. 2017, 13, e1006540. [Google Scholar] [CrossRef]
- Amador, V.; Monte, E.; García-Martínez, J.-L.; Prat, S. Gibberellins Signal Nuclear Import of PHOR1, a Photoperiod-Responsive Protein with Homology to Drosophila armadillo. Cell 2001, 106, 343–354. [Google Scholar] [CrossRef]
Disclaimer/Publisher’s Note: The statements, opinions and data contained in all publications are solely those of the individual author(s) and contributor(s) and not of MDPI and/or the editor(s). MDPI and/or the editor(s) disclaim responsibility for any injury to people or property resulting from any ideas, methods, instructions or products referred to in the content. |
© 2025 by the authors. Licensee MDPI, Basel, Switzerland. This article is an open access article distributed under the terms and conditions of the Creative Commons Attribution (CC BY) license (https://creativecommons.org/licenses/by/4.0/).